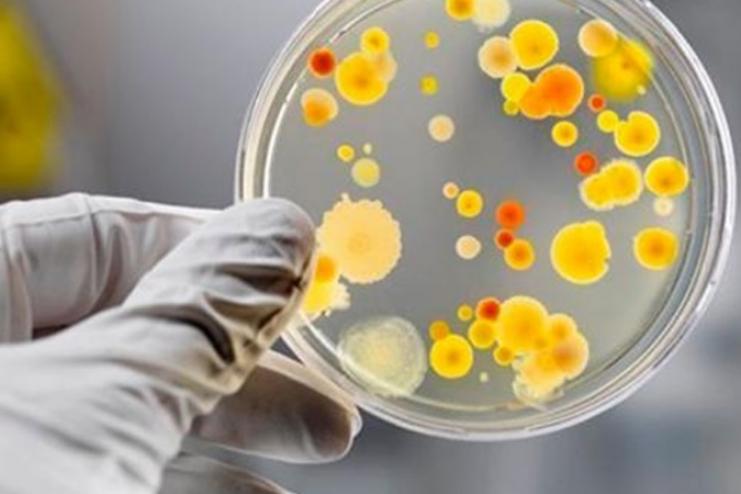

Небезпечний "ТІРАМІСУ": в Одесі збільшилась кількість хворих на сальмонельоз
Станом на 15 липня в Одесі зареєстровано 31 хворого на сальмонельоз, у тому числі 7 дітей.
Як повідомили у прес-службі Одеського обласного центру контролю та профілактики хвороб МОЗ, захворюваність викликана вживанням кондитерського виробу «Тірамісу», придбаного в одній із мереж супермаркетів.
Зазначається, що у період з 8 по 15 липня госпіталізовано 29 хворих, у тому числі 7 дітей. Двоє хворих перебувають на амбулаторному лікуванні. Перебіг захворювання середньої тяжкості. Виписали двох хворих, їх одна дитина.
За даними лабораторних досліджень, у 20 хворих, у тому числі у трьох дітей, виділена сальмонела Ентеритидіс.
З метою встановлення джерела та факторів передачі проведено раптові бактеріологічні обстеження 17 працівників кондитерського цеху, обстежено 6 контактних осіб із хворими у сім'ях; відібрано 28 проб харчових продуктів, 40 змивів з об'єктів довкілля та 1 пробу питної води (матеріал ще в роботі).
За попередніми даними від персоналу цеху, з кондитерського виробу «Тірамісу» та зі змиву з об'єктів зовнішнього середовища цеху виділено сальмонелу.
Ідентифікація біологічних патогенних агентів продовжується.
✅ Стань частиною спільноти «Кут огляду» в facebook та запроси друзів!
«Кут огляду» ближче до читача!
✅ Коротко і по суті. Підпишись на наш Telegram-канал
✅ Підтримай нас в Instagram